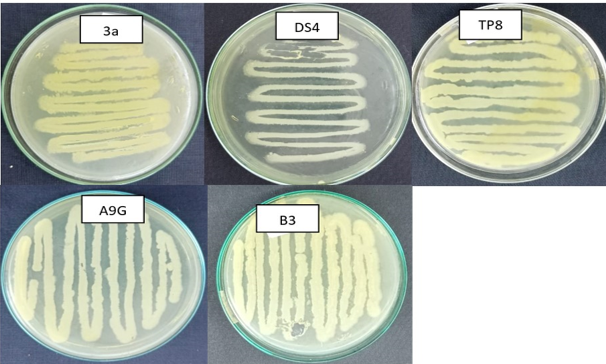

Author Guidelines
Plagiarism
Plagiarism is the use or close imitation of the language and ideas of another author and representation of them as one's own original work. Duplicate publication, sometimes called self-plagiarism, occurs when an author reuses substantial parts of his or her own published work without providing the appropriate references. The similarity index of the manuscript will be checked (must be less or equal than 18%) before sending for the review process. If plagiarism will be found after publication, the SCIENTIFIC PRESS (SMC-PRIVATE) LIMITED will contact the author’s institute and funding agencies for necessary actions and plagiarism will be mentioned on published manuscript.
The manuscripts should be written in English with Cambria font set at size 10 and with single spacing
Tittle (15- 20 words)
The title of a paper serves as a concise summary of its content, highlighting its main focus and purpose. It should effectively communicate the key aspects of the research study, including the topic, scope, and relevance. A well-crafted title should be clear, descriptive, and engaging, enticing readers to delve into the paper. A shorter title is often more effective in grabbing readers' attention and conveying the main idea efficiently.
List of Author(s)
Complete Name: Muhammad Fahim Abbas
Affiliation: Department of Plant Pathology, Faculty of Agriculture, Lasbela University of Agriculture Water and Marine Sciences
Email address: fahim.abbas@luawms.edu.pk
Contract information: 0923334186020
Corresponding Author’s email address: wjb@sciplatform.com
Authors’ Contribution
Author contribution refers to the specific roles and contributions made by each author to the research study or paper. This typically includes activities such as conceptualization, methodology development, data collection, analysis, writing, review, editing, and funding acquisition. Clearly delineating each author's contributions ensures transparency and accountability in research collaboration and proper acknowledgment of individual contributions to the work.
ABSTRACT (250 to 300 words)
The abstract encapsulates the essence of the research study, offering readers a comprehensive overview of its scope, methodology, findings, and implications. By distilling the essence of the research into a concise and coherent narrative, the abstract serves as a valuable tool for researchers, scholars, and practitioners seeking to understand, evaluate, and build upon the findings of the study.
- In a well-crafted abstract, several crucial points should be included to effectively summarize the research study. Here's how each point might be articulated within a 250 to 300-words.
- It provides a succinct overview of the research study, beginning with a concise introduction to the topic and its importance. It establishes the context by elucidating the broader relevance of the research within the field or discipline. By contextualizing the study, readers can grasp its importance and relevance, thereby setting the stage for the subsequent discussion.
- Following the introduction, the abstract outlines the main objective or purpose of the research. This serves to clarify the specific aim or focus of the research, guiding readers towards understanding the central inquiry that the study seeks to address.
- Next, the abstract delineates the methodology employed in conducting the research. It describes the research design, data collection methods, and analytical techniques utilized, providing readers with insights into the study's approach and methodology.
- The abstract provides a summary of the main findings or outcomes of the research. It succinctly encapsulates the key results and significant findings of the study, highlighting any noteworthy trends, patterns, or correlations observed in the data.
- By elucidating the broader implications of the research, the abstract underscores its contribution to advancing knowledge and understanding within the field.
Keywords (Five or more)
Keywords in a paper are terms or phrases that succinctly encapsulate its main topics or themes, aiding in indexing and search ability. It's important to note that keywords should not duplicate words already present in the title, ensuring a broader coverage of the paper's content.
INTRODUCTION
The introduction of a paper serves as the gateway to the research, providing readers with essential background information and setting the stage for the study. Overall, the introduction plays a crucial role in orienting readers to the research topic, establishing its significance, and outlining the purpose and scope of the study. By providing this foundational framework, the introduction prepares readers to engage with the subsequent sections of the paper and understand its contribution to the field.
- It begins by contextualizing the research topic within the broader field or discipline, highlighting its significance and relevance. This often involves discussing previous research or theoretical frameworks to establish the context and demonstrate the existing knowledge base.
- Next, the introduction identifies the research gap or problem that the study seeks to address, pinpointing areas where further investigation is needed. By delineating the gap in knowledge or understanding, the introduction underscores the rationale for the study and justifies its importance.
- Furthermore, the introduction outlines the specific objectives or aims of the research, clarifying what the study sets out to achieve. This may include stating the research questions or hypotheses that guide the investigation, providing a clear roadmap for the reader.
- Additionally, the introduction may briefly preview the methodology or approach that will be employed in the study, offering insights into how the research will be conducted.
OBJECTIVES
The objective of a study articulates the specific goals or purposes that the research aims to accomplish. In a 200-word statement, the objectives should succinctly outline what the study seeks to achieve and how it intends to contribute to knowledge or address a particular research gap.
- The objective of a study should clearly articulate the specific goals or purposes that the research aims to achieve. Objectives are typically selected based on the research problem being addressed, aiming to provide a focused direction for the study.
- They objective should be specific, measurable, achievable, relevant, and time-bound (SMART).
- The objectives guide the research process and ensure that the study's findings contribute meaningfully to knowledge or practice within the field.
MATERIALS AND METHODS
The "Materials and Methods" section should detail the procedures and techniques used to conduct the research, enabling replication and validation of the study.
- It begins by describing the materials, including equipment, instruments, and reagents, specifying their sources and characteristics. Next, it outlines the experimental design or research methodology, including sampling procedures, study participants (if applicable), and any interventions or treatments administered.
- The section then elucidates the data collection process, detailing data collection instruments, variables measured, and data acquisition methods.
- Additionally, it describes any statistical analyses or data processing techniques applied to the collected data. It's important to provide sufficient detail to allow other researchers to replicate the study accurately.
- However, avoid unnecessary minutiae or irrelevant information. Clear, concise, and well-organized presentation of the materials and methods enhances the credibility and reproducibility of the research.
RESULTS AND DISCUSSIONS
The "Results" section presents the findings of the study in a clear and concise manner, typically through text, tables, and figures. It should begin by providing a brief overview of the data collected and the main outcomes of the study. Results are usually organized logically, following the same order as the research objectives and methodology. Each finding should be presented objectively, without interpretation or speculation.
The "Discussion" section interprets the results within the context of existing literature, theoretical frameworks, and the study's objectives. It analyzes the significance of the findings, identifies patterns or trends, and explores potential explanations for observed outcomes. Additionally, the discussion evaluates the implications of the results, considering their relevance to theory, practice, or future research. Any limitations of the study should be acknowledged, along with suggestions for addressing them in future research. Overall, the discussion section synthesizes the findings, contextualizes them within the broader field, and offers insights into their meaning and significance.
CONCLUSIONS
The conclusion should succinctly summarize the main findings, interpret their significance, acknowledge limitations, and propose recommendations for future research or practice. It reinforces the study's contribution to the field and emphasizes its relevance, leaving readers with a clear understanding of the study's implications and potential impact.
CONFLICT OF INTEREST
Authors should declare any potential conflicts of interest.
ACKNOWLEDGEMENT (if any)
The current study was conducted under the project number PSF-12432 funded by Pakistan Science Foundation.
ETHICAL RESPONSIBILITY
This manuscript is original research, and it is not submitted in whole or in parts to another journal for publication.
INFORMED CONSENT
The author(s) have reviewed the whole manuscript and approved the final version of the manuscript before submission.
REFERENCES
The journal is using Endnote reference software for references. Download the journal's template for EndNote reference software by clicking here.
International System of Units (SI units) should be used to abbreviate the units. Tables and figures should be in editable form where applicable.
Figure 1: The bacterial strains selected for the current study i.e., B. cereus (3a), P. aeruginosa (DS4), B. nitratireducens (TP8), E. cloacae (A9G) and Pseudomonas sp. (B3).
Table 1. Recorded diversity indices of butterflies in Ghamot National Park during 2020-21
Zones | Species (S) | Individuals (N) | Simpson | Shannon (H) | Evenness (J) |
FZL1 | 11 | 91 | 0.90 | 3.35 | 0.97 |
FZL2 | 10 | 73 | 0.89 | 3.27 | 0.99 |
FZL5 | 15 | 102 | 0.92 | 3.77 | 0.97 |
SLZL2 | 12 | 70 | 0.90 | 3.44 | 0.96 |
SLZL3 | 13 | 74 | 0.91 | 3.61 | 0.98 |
RZL2 | 8 | 38 | 0.88 | 3.02 | 1.01 |
APZL1 | 12 | 59 | 0.89 | 3.38 | 0.94 |
ACZL1 | 10 | 32 | 0.89 | 3.29 | 0.99 |
Key: Forest zone “FZ”, scrubland zone “SLZ”, riparian zone “RZ”, Alpine zone “APZ”, Agricultural crop zone “ACZ”. localities “L”
Proofread Version: After satisfactory revision and acceptance, the electronic proof read version of final manuscript will be sent to author(s) and only minor corrections in the text are allowed before publication. The final manuscripts will be available online but it will be published on its turn.